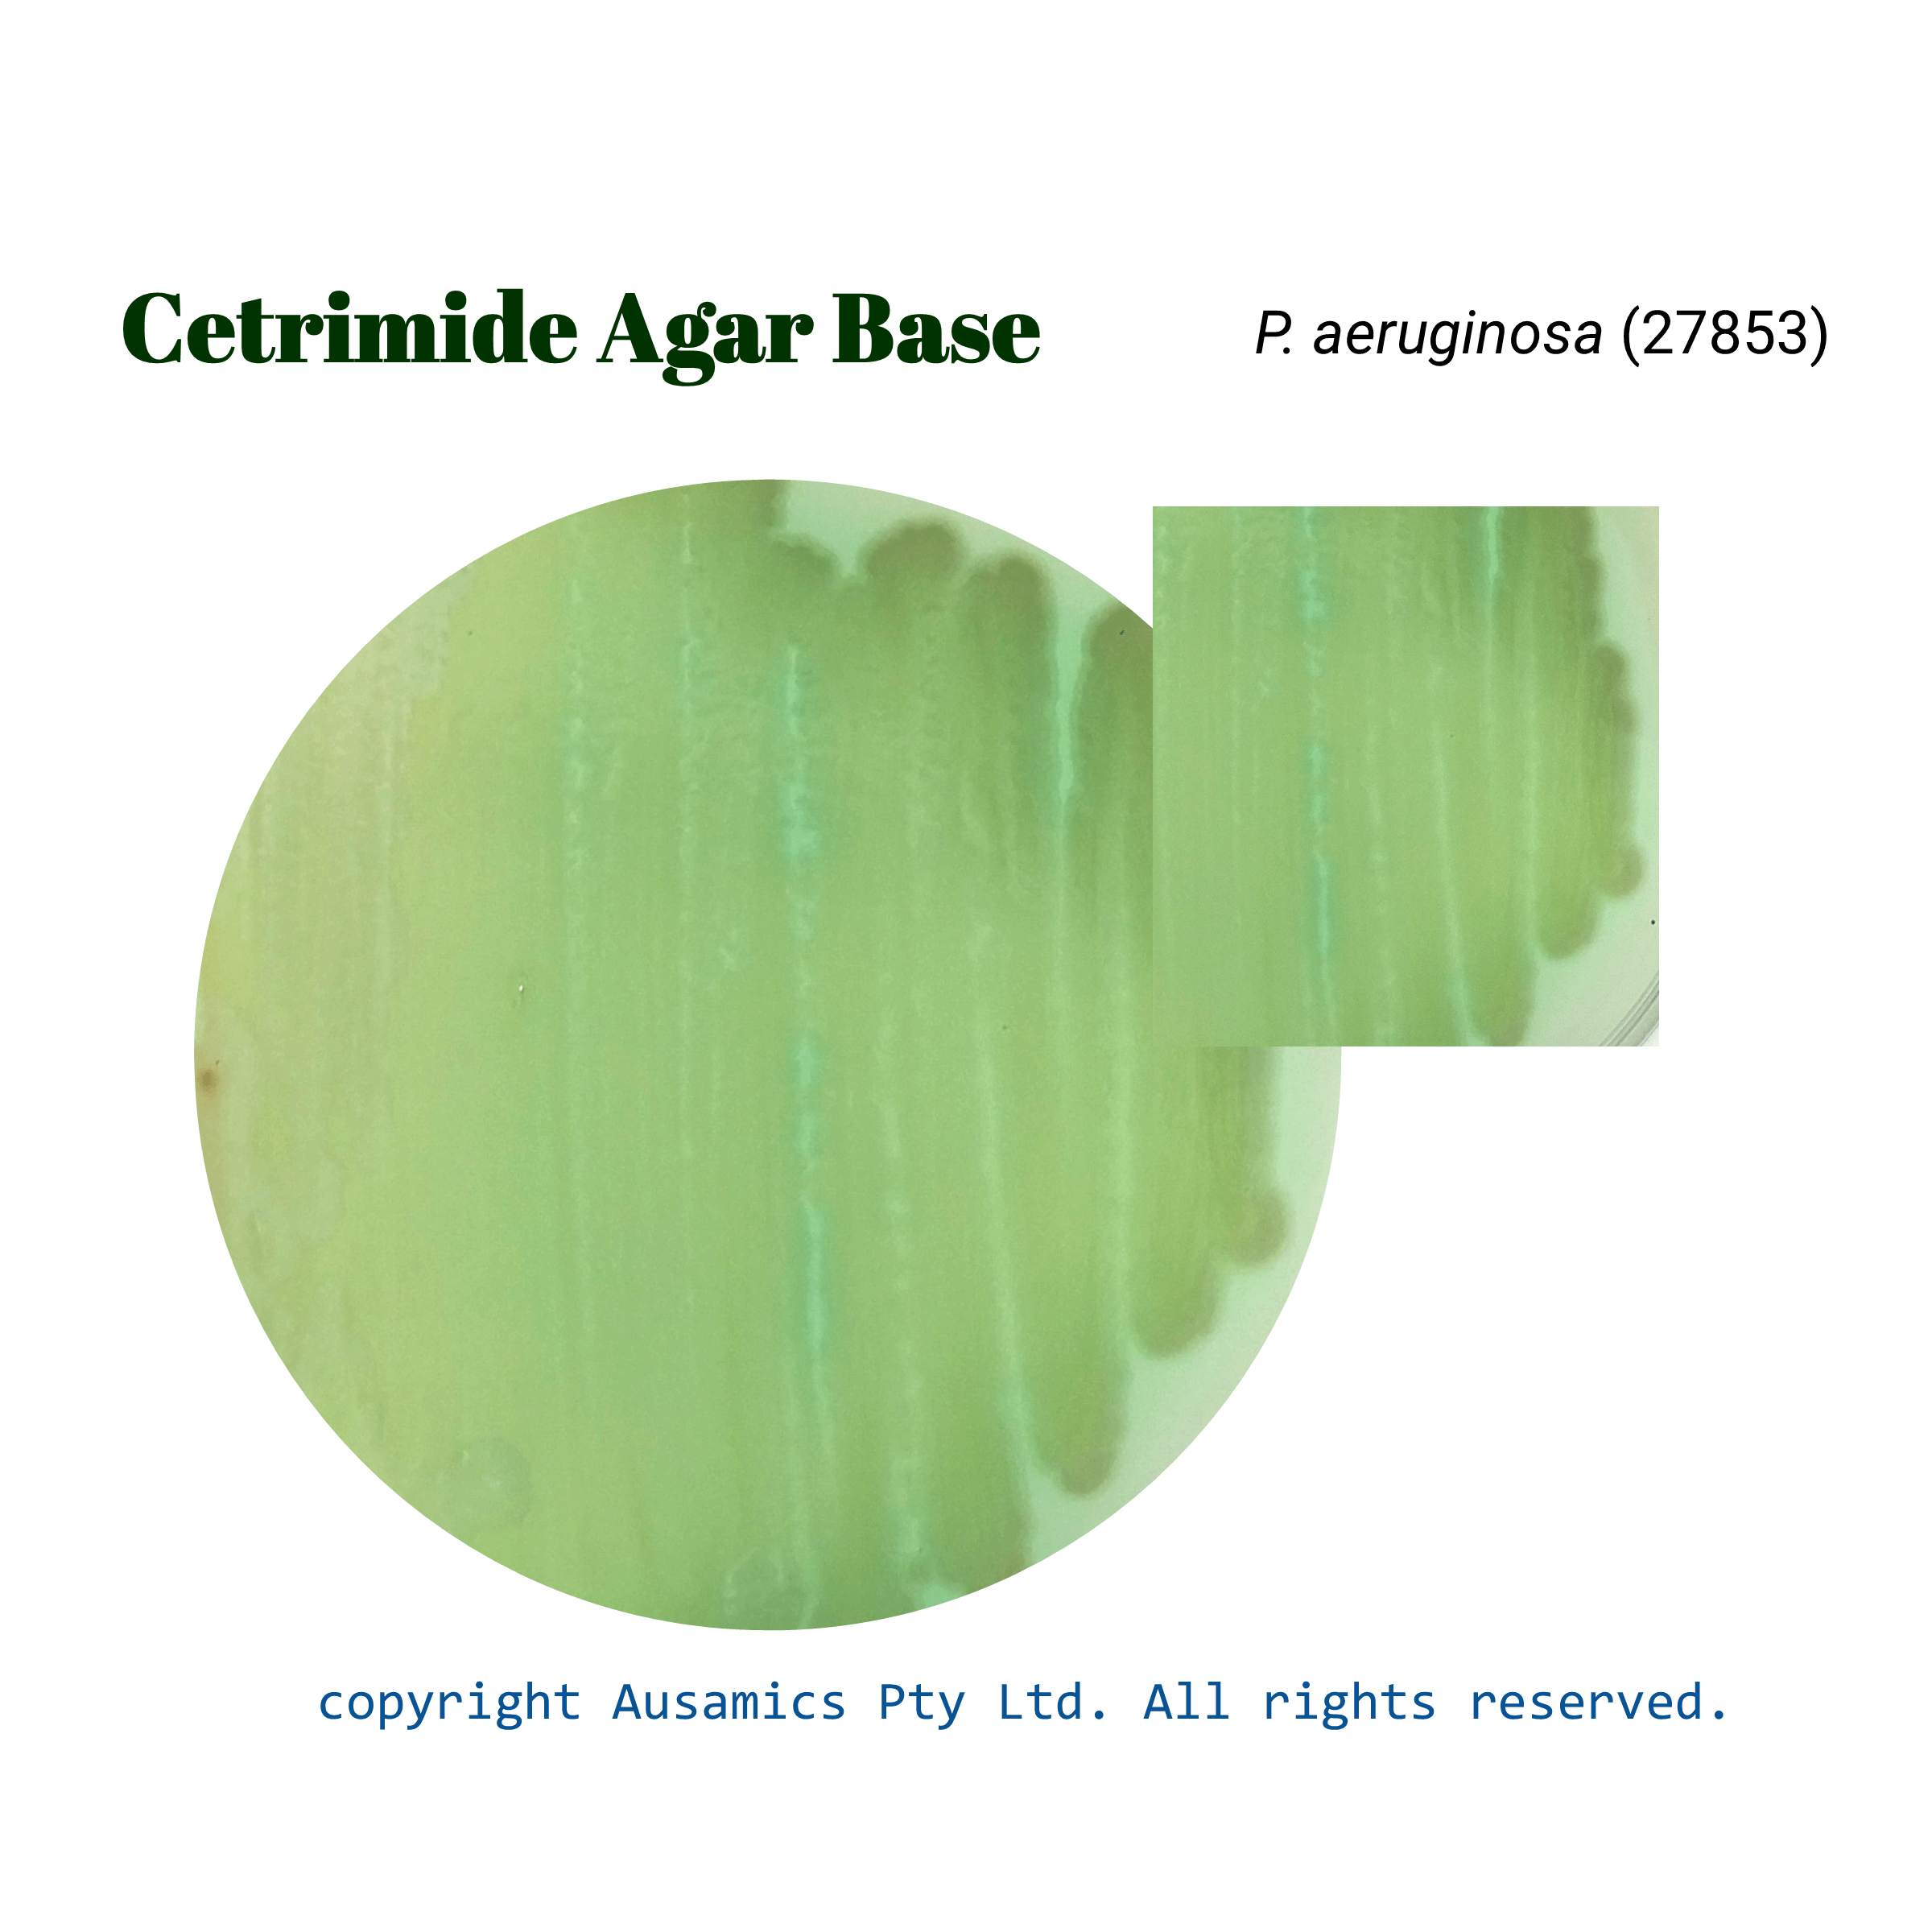

Cetrimide Agar Base
Used for the selective isolation and identification of Pseudomonas aeruginosa.
- Description
- Composition
- Quality Control
- Microbial Test Results
Cetrimide agar is a selective culture medium used to isolate and presume the identity of Pseudomonas aeruginosa. This medium helps P. aeruginosa recover by preventing the majority of contaminated microbiota from growing.
A quaternary ammonium chemical called cetrimide is added, which causes bacterial cell membranes to disrupt and has a selectively inhibiting effect. Essential nutrients, including gelatin peptone, facilitate the growth of bacteria, and sodium chloride preserves the osmotic balance. Pyocyanin, a distinctive blue pigment made by P. aeruginosa, is enhanced by the addition of magnesium chloride and potassium sulfate. The production of this pigment facilitates the organism’s presumed identification. In clinical, environmental, and industrial microbiology, cetrimide agar is frequently used to identify and count P. aeruginosa.
Storage
Keep the container at 15-30 °C and prepared medium at 2-8 °C
| Composition | gr/L |
| Pancreatic Digest of Gelatin | 20 |
| Magnesium Chloride | 1.4 |
| Potassium Sulfate | 10 |
| Cetrimide | 0.3 |
| Agar | 13 |
| Final pH at 25°C | 7.2 ± 0.2 |
| Dehydrated Appearance | Beige, free-flowing, homogeneous. |
| Prepared Appearance | Light amber, opalescent, with precipitate. |
| Reaction of 4.47% Solution at 25°C | pH 7.2 ± 0.2 |
| Incubate at 35 ± 2°C for 24 to 72 hours. Incubate P. aeruginosa ATCC 9027 and ATCC 27853 at 30 to 35°C for 48 to 72 hours. | ||
| Organism (ATCC) | Recovery | Yellow-Green Pigment |
| Pseudomonas aeruginosa (27853) | Good | Yellow-green |
| Pseudomonas aeruginosa (9027) | Good | Yellow-green |
| Staphylococcus aureus (25923) | Inhibition | – |
| Escherichia coli (25922) | Inhibition | – |
| Escherichia coli (8739) | Inhibition | – |